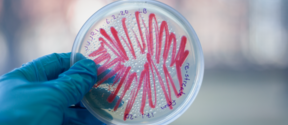
Bacteria_PhotoBy_EveliinaJuuri

Regenerative Binderless Panels from Baltic Reed by Hana Rehorčíková
How design-led material innovation can contribute to ecological restoration.

How design-led material innovation can contribute to ecological restoration.

Disassemblability and Reparability in Product Design.

Helping emerging creatives build their career as entrepreneurs in the design field.
Explorations into making sense of a contemporary craft practice.

Proposing a reimagined relationship between humans and fungal materials, within craft and design.

Material research on roadside plants and their suitability as design materials.

Storytelling through investigative design & material development
Authenticity is the foundation of a sustainable and fulfilling creative career - by deepening our connection with our true selves, we unlock new ways of making, expressing, and thriving as creatives. This thesis explores how embracing both our light and shadow shapes a more authentic and meaningful creative practice.

Empirical research of Finnish minerals and a study of the meaning of material origins in the context of art, design and ceramic practice.

This Master’s Thesis explores how a material-oriented designer could better affect the far-reaching consequences of her action by shaping the framework by expanding the scope of the design process from the object's life cycle to the materials' life cycle.

The influence of gap in a creative material process.

The thesis illustrates a practice-led approach to acknowledge and emotionally connect with the Finnish earthenware heritage by encountering brick architecture and picking fragments in the municipalities of Helsinki and Espoo.

How could art and its verbalization live side by side, supporting each other?

Book-writing as Design: Exploration of a hydro-logic process towards a multimodal creative nonfiction

This thesis approaches biochar, a carbon-rich product utilizing waste biomass, using experimental design as a method. The research contains a theoretical and a practical part and aims to understand biochar’s material properties to explore whether applying biochar-based material combinations as an alternative for more carbon-intensive and energy-heavy materials would allow easing up the emissions generated in the production of artefacts.

This Master’s Thesis “Companions for life – an exploration to the emotional dimensions of inanimate objects” is a theory-driven study that consists of a written part and an artistic production.

The role of internships is becoming increasingly dominant in design education as the primary way for design students to bridge the gap between their formal education and professional work. Moreover, internships have become a typical arrangement for young and not-so-young designers to start—and sustain—their career. Yet, design interns’ reports show that for many, internships tend to be exploitative opportunities for employers rather than educational experiences for students, who often end up uncredited, overworked, and underpaid. Additionally, educational institutions offer little guidance on navigating this precarious world.

Being on the brink of graduation, I wanted to take time to truly explore my identity and ways of expressing it through creative work to make my future wishes and possible paths clear. I have studied in the department of design and my interests within this field have always been in the more artistic ways of working. I am progressively gearing towards a fascination with fine arts, which is why I have faced questions about identity and a need to understand how and what I want to express and what would be my way in creativity.

The forest is a widely studied subject in Finland, especially from the standpoints of the forest industry and ecology. However, also a designer is an important link between the material source and the end product or service. Nonetheless, a comprehensive and topical designer's point of view is missing.
This study addresses this gap by aiming to understand the multiple values of the forests and wood as material for the design practices. The goal of the study is also to gather and transmit knowledge and to raise discussion of forests, especially in the field of design. The research question is: how can I as a designer respect forests and wood as a material and apply this understanding to my design?

This thesis investigates the design processes of an innovative biobased material from a designer perspective using flower waste in Bangkok, Thailand as the case study. The research adopts practice-led research as the core methodology to gain an empirical understanding of the material development processes while having the Double Diamond methodology as the research framework.

“Weaving Landscapes” is a research through design thesis that explores the relationship between craft and design, by using concepts from the material culture, with(in) the landscape. Landscape in this thesis refers to the environment(s) in which humans and nonhumans interact. Meanwhile, material culture is the concept that brings together activities from human society and natural ecosystems (natural culture) into one culture. Furthermore, this thesis examines the collaboration that exists between craft and design, which is studied on the notions of preservation and revitalization. In order to find a way to revitalize craft and design I have reviewed craft’s knowledge, values and relationships with the landscape and the raw materials it provides. The context of the thesis is situated in Finland, in the relation that birch bark weaving technique has with the natural environment and with the society.

Soil Care: Symphony Rehearsal is a Master’s thesis project that takes soils as its fundamental focus in a collaborative craft practice in order to reclaim attention for soils in an age of ecological challenges. When focused on soil care, craft making can be considered a dialogical practice for establishing conversations between humans (makers), soils (materials) and the human-soil interaction that exists within the local environment. By utilising the practice-led approach, this research is driven by inquiring into whether collaborative craft practices would provide a different way to re-think and re-evaluate our relationship with soil.
'Pigments of Microorganisms' is a study of microorganisms that are able to produce colourful pigments. Within this thesis work I inspected in depth to laboratory working with the biochemistry scientists and as a designer I implemented a series of material experiments together with the microbial produced colourants.

This research is about the development of the modular glass blowing mold and the usage of the mold for manufacturing glass objects in hot work shop. The modular mold enables countless shapes produced with one mold, which makes the form creation process different from the traditional way. The project is carried out as teamwork; the mold development process, testing and design of the products manufactured are done in full cooperation with Jukka Jokinen and Heikki Konu. The literary work has been divided equally 50-50 between the designers, Jokinen focusing on the mold development and Konu on using the mold in glass blowing process.

Through the designing and making of Kuulas – a wooden low chair with textile components, I examine the development processes by which iterative and explorative methods are employed with research tools through a practice-led research framework. The development of woven textiles and the development of the low chair are narrowed with step-by-step process descriptions and reflections thereof. These foretell how research tools were employed to examine the iterative, explorative processes behind the project development, and to convey the decisions emitted towards the form-language of the Kuulas chair, which the name comes from the Finnish meaning: clear or pure. Throughout development stages of the project, communicative tools and form-finding techniques are developed to best examine furniture/textile making and design processes. These studies indicate the importance of documentation and reflection, as they are present in communicating how thinking and making has evolved throughout the project. Furthermore, this thesis examines how an artist-designer can employ his/her experiences and personal histories to develop abstract concepts for design projects.

The topic of this master’s thesis is the design of a wooden dining chair for Hakola Huonekalu Oy. The aim was to design a chair that can be industrially manufactured in the Jurva area in Southern Ostrobothnia. The chair should complement Hakola’s existing product line in a natural and fresh way, adding more content and value to the customer’s brand. The choice of topic was influenced by the author’s need to diversify his product design expertise and challenge himself to design a product that had not been completely designed before by himself.The focus of this thesis was also on increasing professional knowledge of wood materials, wood furniture production methods, the potential of the domestic furniture industry, ecologically and ethically sustainable design and seating ergonomics.

We Make Effort enquires into personal experiences of aiming to practice feminism collectively in the context of design. The thesis stems from a place in time coloured by a sense of societal urgency, value contradictions with practicing as a designer, and not quite knowing how to negotiate them. It unfolds some personal, professional and political meanings of engaging with feminist theory and collectivity, as well as the consequent shifts in conceiving practice in the field of design.